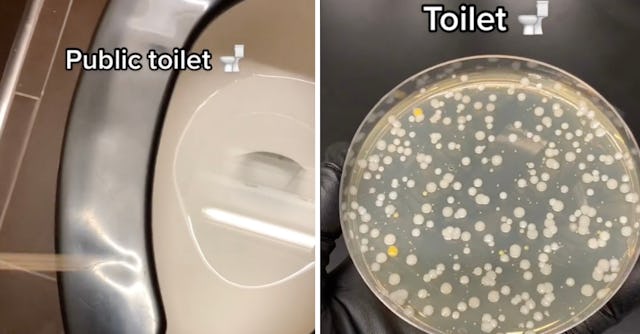
A masters student at the University of Toronto is sampling and culturing everyday objects to see jus...

A Biology Student Is Sharing her Quest To Find All The Top Places That Germs Grow
A Master’s student shared her findings with her 300k followers.
Ever wondered about what kind of germs lurk on a public toilet seat or dollar bill? One science student at the University of Toronto is studying just that — and she’s posting all of her disgusting findings to TikTok.
TikTok user @the_lab_life1 takes samples from everyday objects like coins, a bare foot, and a subway seat, grows the sample in an incubator and then posts the results to see if anything did, in fact, grow from her sample.
Sometimes, she takes suggestions from her followers while other times she uses her coworkers for help. These insightful (but also sometimes super gross videos) allow followers to get a sneak peek into the secret world of the germs that live around us.
The student — who goes by CM — told Newsweek that her viral series was all an accident while working to get her Master’s of Science in biomedical sciences.
“My research is microbiology focused where I am studying the breast milk microbiome and the way it impacts infant health,” she said. “I am basically looking at the bacteria in healthy breast milk and linking it to the development of healthy infant microbiomes.”
In October 2022, CM shared a video of the different bacteria she was able to grow from her lab members' skin, the video took off, receiving over 3 million views.
Now, CM has a "What Will Grow?" TikTok series where she tests all sort of every day objects to see what grows. “Once I swab something using a sterile cotton tip applicator, I will spread it onto a nutrient agar plate which, supports bacterial growth,” she said.
As for her online virality, she believes that people just have an instinctual fascination to learn more about the things that cannot be seen with the naked eye.
"I find that people, including me, have a natural interest to see what they normally can't, so I thought why not try to show them?," CM told Newsweek. "As I used to be what one would call a 'germaphobe,' doing these videos actually makes me less scared.
"Everything will always have some sort of microbiome on it, but I have learned to accept that. It's like the bacteria have their own little lives and cities, but instead it's on an apple."
So, although every object does have some sort of microbiome on it, what about the not-so-fun microbes, like bacteria and viruses? MC shared the top five most alarming cultures she discovered from her experiments.
First, MC noted that the bottom of a fellow lab member’s shoe made the list because she works in a dentist’s office. “...she is stepping on a lot of different organisms all day long, but the plate that resulted really did gross me out,” she said.
To no one’s surprise, the germs that grew from the sample taken from a dog’s mouth had a particular smell that she’ll never forget. Her bosses wallet and a water fountain also made the top five for most germs.
However, it was the sample from the public toilet seat that took the cake.
“Swabbing a public toilet in itself is quite gross, so I definitely didn't love that one. Considering that it was from a toilet, the bacteria that grew were not very icky, but the plate did grow a lot of different bacteria, which is always fun to see because of all the different colors and shapes,” she said.
MC listed E. coli, E. faecalis, and Staphylococcus as just a few of the bacterias found on the toilet seat. So now that you’ve read this, you’ll either line that seat with layers upon layers of toilet paper or squat like your life depends on it.
One user who commented on the video went to even more drastic measures. “Never using a public toilet again lmao,” they wrote.
My thoughts exactly!
This article was originally published on